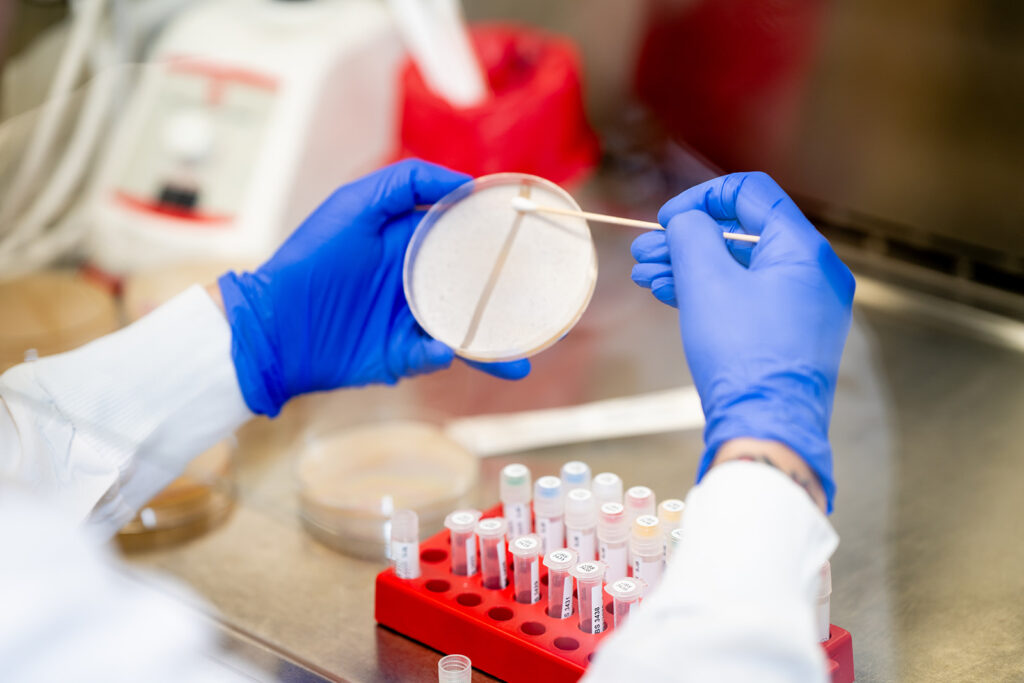

From growing up on a farm and leading innovation in ag, I’ve learned consistency is king. Farmers depend on solutions that deliver, acre after acre, season after season. As the biologicals sector matures, ensuring consistent performance—across products, geographies, and seasons—has become both our biggest challenge and our greatest opportunity.
I recently returned from the 2025 Salinas Biological Summit in Woodland, California. Being in a room full of people as passionate and determined as I am about the potential of biologicals was inspiring. The conversations during coffee breaks and stories from growers and researchers made one thing clear: everyone wants solutions that work—not just in trials, but on real farms. Hearing about others’ ups and downs with consistency hit home. We’re all learning, and the push for reliability is personal for everyone in the field.
Consistency in biologicals is not achieved in the lab alone. It is proven in the field—across diverse soils, climates, and practices. To get there, we must move beyond the chemistry mindset where we were applying products at the same rate, on every acre, and expecting chemistry-like outcomes. That worked for chemicals, but biologicals include living organisms. They interact and adapt. Treating them like chemicals misses the point—and misses their potential.
That’s why we took a different approach. Our team at Jord BioScience is implementing a new playbook, focused on the science of microbes – how they interact in the soil for the benefit of crops. We have recently reviewed multi-year field trials from across 16 Midwest locations, testing our proprietary microbial leads in soybean seed treatments. The results? With the right partner microbes, we see yield increases of up to 3.1 bushels per acre over the commercial standard, even in wildly different weather. By understanding the relationships among biologicals, our solutions outperformed leading biological and chemical benchmarks by 11% to 25%, with win-rates over 80%. That’s real, repeatable consistency.
Coming back to lessons from the Salinas Summit, I was impressed by the emphasis on collaboration – between biologicals companies, growers, researchers, regulators, and policymakers. It is clear there is an appetite for change, and for leveraging strengths to make progress. At Jord, we believe the same; one of our core values is Collaboration. Through partnerships (between microbes and in business), we can accelerate adoption and deliver on the promise of sustainable, reliable solutions for growers.
The path to consistency demands a shift in innovation:
- Leverage diverse microbial libraries: Tapping into global diversity helps identify robust, compatible strains.
- Use advanced analytics: Data-driven insights reveal which combinations work best across diverse environments.
- Partner with growers: On-farm trials and feedback loops are critical for real-world validation.
Farmers deserve biologicals that are as dependable as the best chemistries. Consistency isn’t a buzzword. It’s the foundation for trust, adoption, and ultimately, better outcomes for growers. And we’re just getting started.